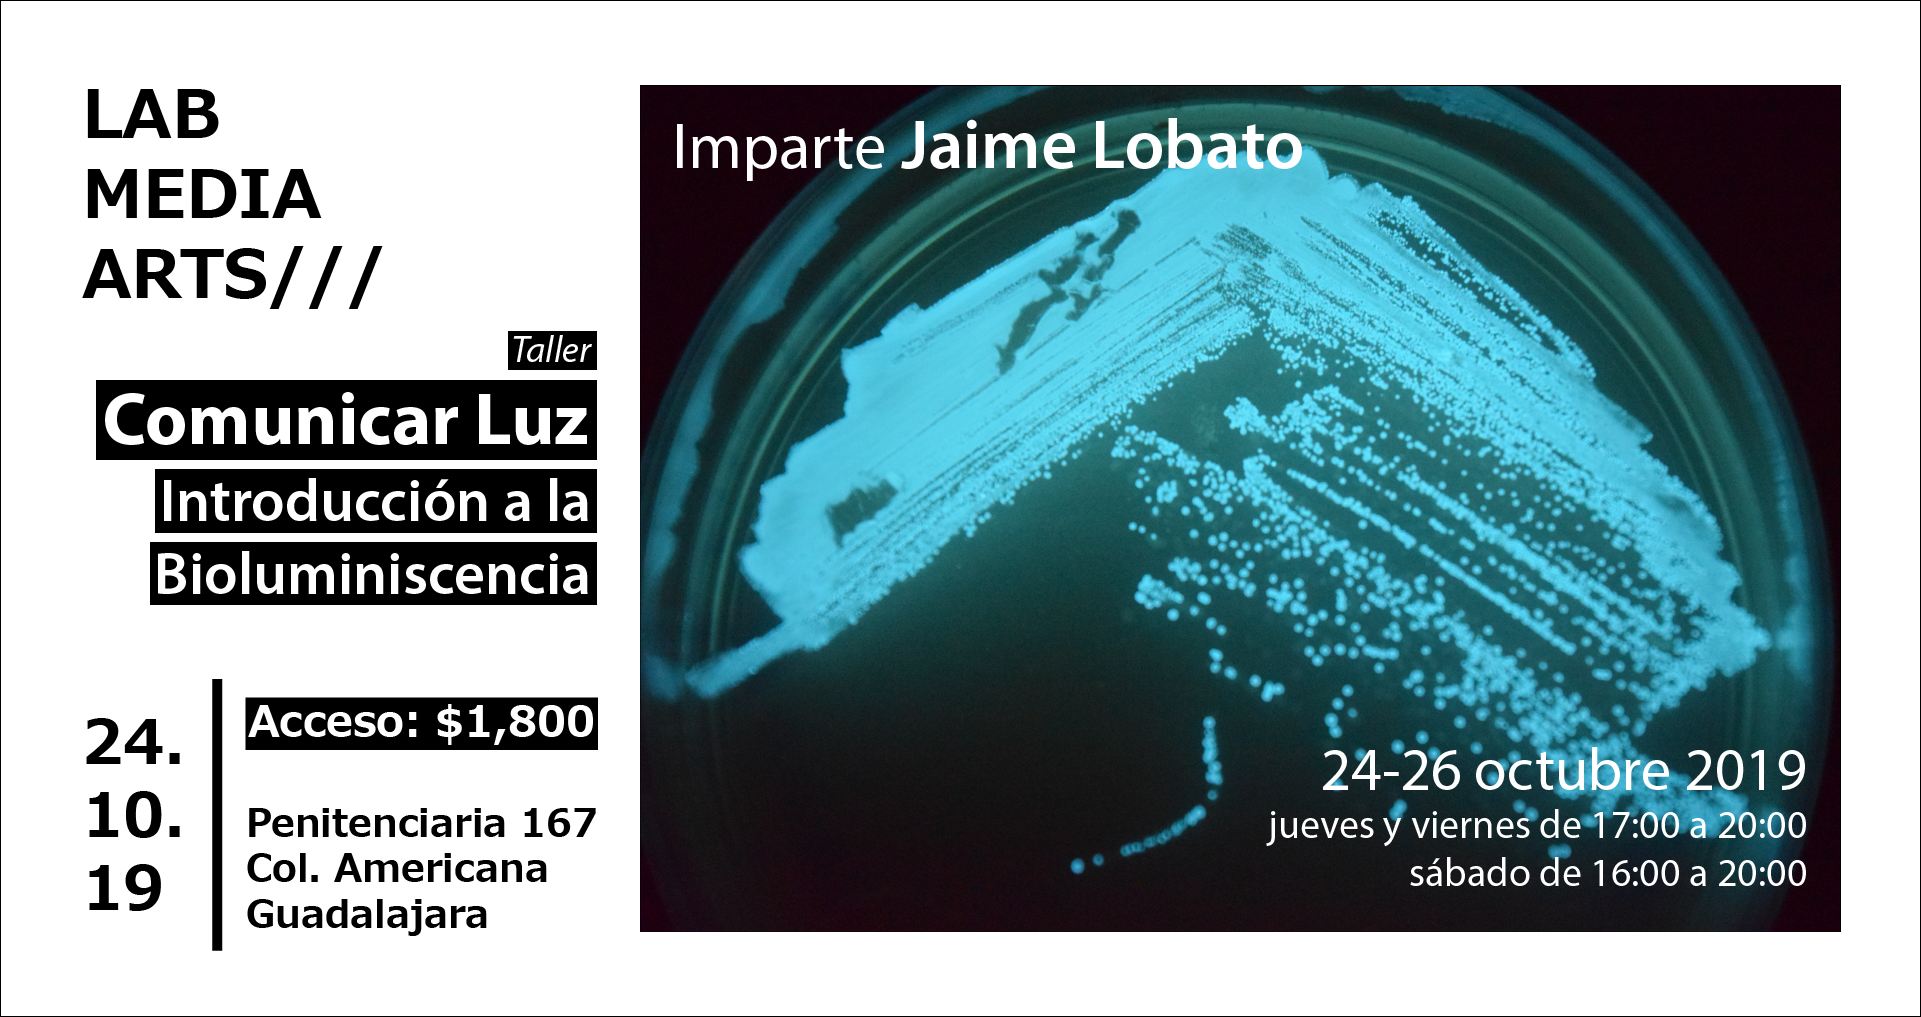
Image

Comunicar Luz - Introducción a la Bioluminiscencia
La bioluminiscencia es la creación de energía lumínica por entes biológicos a través de reacciones bioquímicas. En la naturaleza, es utilizada con fines muy diversos que van desde reproducción, estrategias de caza, hasta camuflaje. En la investigación científica se ha utilizado para detectar reacciones acopladas en tiempo real, como por ejemplo la secuenciación de DNA y el seguimiento de la expresión génica. El conocimiento de este proceso natural ha sido utilizado por el hombre desde tiempos inmemoriales y ahora en el contexto del bioarte como medio para nuevas creaciones y reflexiones.
Este curso teórico/práctico es una introducción al trabajo de laboratorio para realizar el protocolo de aislamiento de microorganismos bioluminiscentes. Ya aislados, crearemos una obra viva y revisaremos la historia de la relación del hombre con este fenómeno. A través del arte nos acercaremos a conceptos en torno a la vida, la biología y la ciencia de manera lúdica y divertida.
Dirigido a:
- Artistas.
- Diseñadores.
- Arquitectos.
- Biólogos.
- Público en general con interés en la ciencia, biología y bioarte.
Objetivos del taller:
- Aprender las técnicas básicas de microbiología para aislar organismos bioluminiscentes de calamar californiano.
- Conocer la importancia de la bioluminiscencia en el ámbito natural y sus aplicaciones en la investigación.
- Conocer el concepto y la historia del bioarte y crear una obra bioluminiscente.
Duración del taller:
- 10 horas.
Fechas del taller:
- Jueves 24 de Octubre de 17:00 a 20:00.
- Viernes 25 de Octubre de 17:00 a 20:00.
- Sábado: 26 de Octubre de 16:00 a 20:00.
Sede:
- LAMA – Laboratorio Media Arts.
- Calle Penitenciaría 167 Col. Americana.
- Guadalajara, Jalisco.
- A media cuadra del Parque Rojo, casi esquina con López Cotilla.
Costo del taller:
- $1,800.00 MXN.
- Incluye materiales.
Requerimientos para el participante:
- Ninguno.
- No se requiere conocimientos previos en biología o trabajo de laboratorio.
Temario:
- Introducción al bioarte.
- Historia de la bioluminiscencia.
- Equipo y seguridad en el laboratorio.
- Técnicas de asepsia y esterilidad.
- Técnicas de microbiología. Aislamiento de microorganismos.
- Anatomía básica del calamar californiano y su relación con los microorganismos bioluminiscentes.
- Preparación de medios de cultivo.
- Aplicaciones en diseño.
- Aplicaciones biotecnológicas.
- Cultivos bioluminiscentes aislados.
- Ejercicios de bioluminiscencia y dibujo.
- Bioplásticos.
Regístrate aquí:
https://forms.gle/rShsQz6xEBJWJaqB8
Jaime Lobato

Compositor, artista multimedia y curador independiente. Estudió composición en la Escuela Nacional de Música (Mx). Ha compuesto música para video, instalaciones interactivas, piezas electroacústicas mixtas, danza, poesía sonora y performance. Su obra va desde la composición contemporánea, hasta el performance, pasando por el arte digital e interactivo. Ha tenido dos muestras individuales, en el Espacio de Experimentación Sonora en el Museo Universitario de Arte Contemporáneo “Tactosis!” (MUAC-UNAM) y en el Laboratorio Arte Alameda. Entre sus proyectos ha colaborado con artistas de América, África y Europa. Se ha presentado en foros como: Experimentaclub (España), El Callejón del ruido (Mex), La Habitación del Ruido (Mex), el Centro Cultural de España (Perú), Museo Nacional de Bellas Artes (Cuba), MediaLab-Prado (España), Circuito Electrovisiones (Mex), Plataforma Transónica, Festival Internacional Cervantino (Mex), Pdcon (Alemania) y Lab for Electronic Art and Performance LEAP (Alemania). Es miembro fundador de [radiador] y SEMIMUTICAS Seminario de Investigación en Música Matemáticas y Computación. Trabajó en el departamento de Visualización Científica y en el Observatorio de Realidad Virtual Ixtli, ahora colabora en proyectos de investigación del Instituto de Investigaciones Estéticas (IIE-UNAM) y en el Instituto de Investigaciones en Matemáticas Aplicadas y en Sistemas (IIMAS-UNAM).
Independencia BioLab

Espacio de biohacking ubicado en la Ciudad de México que cuenta con herramientas de experimentación en biología molecular, química, bioseñales y electrónica. A partir de una mirada independiente y crítica se pretende socializar estos saberes para empoderar a la comunidad sobre uno de sus patrimonios más importantes: “la vida”. Arte, pensamiento y biología son conceptos centrales de esta iniciativa.
Las actividades que se realizan en este laboratorio independiente de ciencia ciudadana son: investigación en biotecnología desde la perspectiva del biohacking; creación artística, que incluye proyectos de arte híbrido, performance audiovisual en tiempo real, arte sonoro y tactical media; cursos, talleres y diplomados; así como asesorías y residencias de producción.
Está conformado por Jaime Lobato, Alfonso Castillo y Tadeo Valencia.